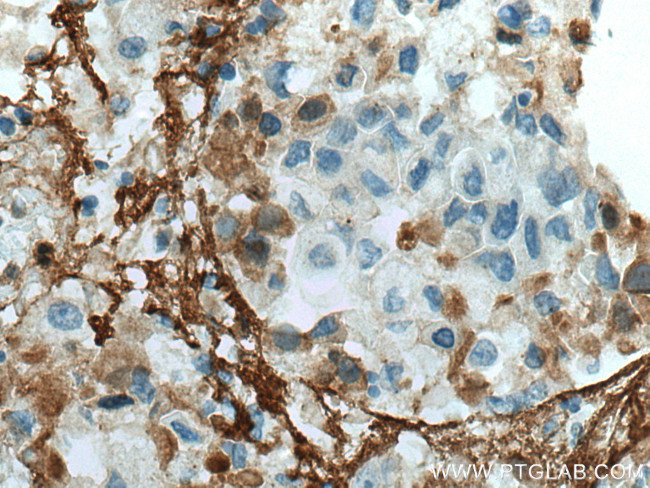
Collagen Type V Antibody in Immunohistochemistry (Paraffin) (IHC (P))

Search
Proteintech
Collagen Type V Monoclonal Antibody (2C2C2)
{{$productOrderCtrl.translations['antibody.pdp.commerceCard.promotion.promotions']}}
{{$productOrderCtrl.translations['antibody.pdp.commerceCard.promotion.viewpromo']}}
{{$productOrderCtrl.translations['antibody.pdp.commerceCard.promotion.promocode']}}: {{promo.promoCode}} {{promo.promoTitle}} {{promo.promoDescription}}. {{$productOrderCtrl.translations['antibody.pdp.commerceCard.promotion.learnmore']}}
产品信息
67604-1-IG
种属反应
宿主/亚型
分类
类型
克隆号
抗原
偶联物
形式
浓度
规格
纯化类型
保存液
内含物
保存条件
运输条件
产品详细信息
Aliquoting is unnecessary for -20°C storage.
靶标信息
Type I collagen, the fibrillar collagen found in most connective tissues, and the only component of the collagen found in cartilage. Mutations in this gene are associated with osteogenesis imperfecta, Ehlers-Danlos syndrome, and idiopathic osteoporosis. Reciprocal translocations between chromosomes 17 and 22, where this gene and the gene for platelet-derived growth factor beta are located, are associated with a particular type of skin tumor called dermatofibrosarcoma protuberans, resulting from unregulated expression of the growth factor. Two transcripts, resulting from the use of alternate polyadenylation signals, have been identified for this gene.
仅用于科研。不用于诊断过程。未经明确授权不得转售。
生物信息学
蛋白别名: alpha1(V) collagen; collagen alpha 1 (V); Collagen alpha-1(V) chain; collagen type 5 alpha 1; collagen, type V, alpha 1; pro-alpha1(V) collagen; procollagen alpha 1(V); procollagen type V alpha 1; procollagen, type V, alpha 1
基因别名: AI413331; COL5A1; EDSC; EDSCL1; FMDMF
UniProt ID: (Human) P20908, (Mouse) O88207, (Rat) Q9JI03
Entrez Gene ID: (Human) 1289, (Pig) 397533, (Mouse) 12831, (Rat) 85490